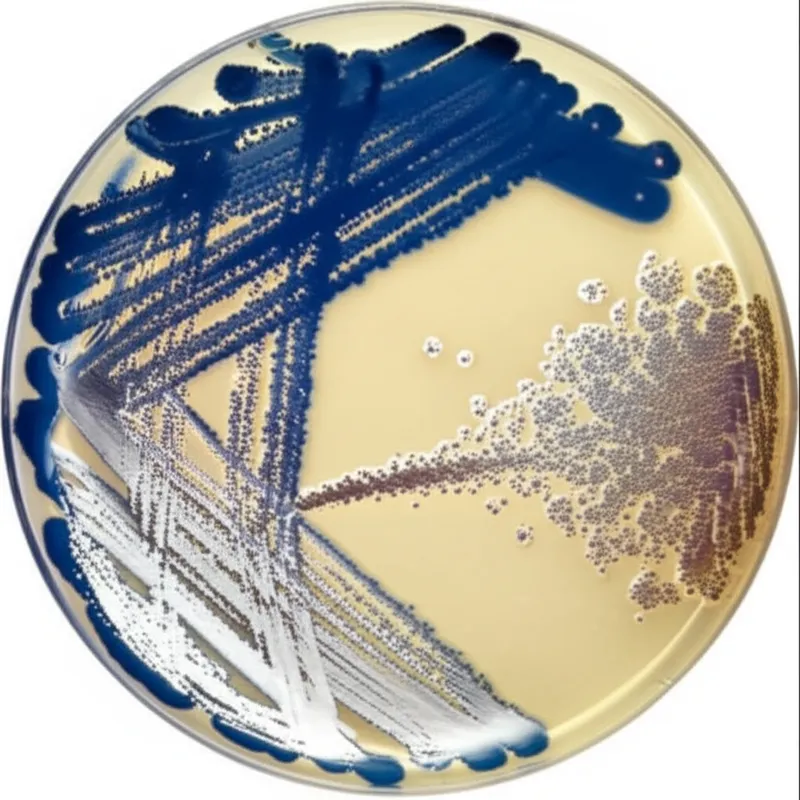
substrain

microorganism
इमर्सिव विज़ुअल्स और AI के माध्यम से शब्दावली मास्टर करें

siderophorenoun
/ˈsaɪdərəˌfɔːr/ /ˈsaɪdərəˌfoʊr/
साइडरोफोर

prophagesnoun
/ˈproʊfeɪdʒɪz/
प्रोफेज
"Many bacteria contain prophages within their DNA, remnants of past viral infections that now exist silently as part of the bacterial chromosome. "
कई बैक्टीरिया में उनके डीएनए के भीतर प्रोफेज होते हैं, जो पिछले वायरल संक्रमणों के अवशेष हैं जो अब जीवाणु गुणसूत्र के हिस्से के रूप में चुपचाप मौजूद हैं।

nitrifyingadjective
/ˈnaɪtrɪfaɪɪŋ/
नाइट्रिफाइंग

infectiousadjective
/ɪnˈfɛkʃəs/
संक्रामक, संसर्गजन्य

matrixesnoun
/ˈmeɪtrɪˌsiːz/ /ˈmætrɪksɪz/
संवर्धन माध्यम

paramoeciumnoun
/ˌpærəˈmiːsiəm/ /ˌpærəˈmiːʃiəm/
पैरामीशियम

verticilliumnoun
/ˌvɜːrtɪˈsɪlɪəm/ /ˌvɜːrtɪˈsɪliəm/
वर्टिसिलियम, वर्टिसिलियम वंश के कई कवक में से कोई भी जो पौधों में मुरझाना पैदा करते हैं

antibiosisnoun
/ˌæntiˌbaɪˈoʊsɪs/
एंटीबायोसिस